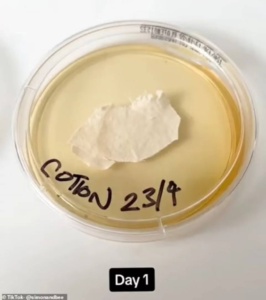
μαξιλαροθήκες
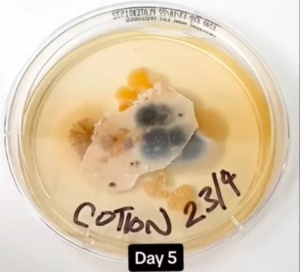

Δραματική προειδοποίηση γιατρού: «Η μαξιλαροθήκη έχει περισσότερα μικρόβια και βακτήρια από το κάθισμα της τουαλέτας» – Πείραμα σοκ, θα πάθετε αυτά τα προβλήματα
Αν είστε από εκείνους που αμελούν να αλλάξουν τις μαξιλαροθήκες, το πείραμα με όσα συσσωρεύουν σίγουρα θα σας πείσει να το κάνετε συχνότερα.
Ορισμένοι τις αλλάζουν κάθε εβδομάδα, άλλοι στις 15 ημέρες και υπάρχουν και εκείνοι που τα αφήνουν για πιο πολύ καιρό.
Μελέτες έχουν δείξει ότι κατά μέσο όρο οι άνθρωποι αλλάζουν ή πλένουν τις μαξιλαροθήκες κάθε 24 ημέρες, ενώ οι δερματολόγοι συνιστούν τουλάχιστον δύο φορές την εβδομάδα.
Ίσως, όμως, μετά από αυτές τις φωτογραφίες αλλάξετε γνώμη και η αλλαγή σεντονιών και μαξιλαροθηκών γίνει η αγαπημένη συνήθεια της εβδομάδας.
Όπως αναφέρει η Daily Mail, αν δεν έχετε πλύνει τις μαξιλαροθήκες σας εδώ και μία εβδομάδα, πιθανότατα κοιμάστε σε 17.000 περισσότερες αποικίες βακτηρίων από αυτές που μπορεί να εντοπιστούν στο κάθισμα της τουαλέτας.
Το τεστ στις μαξιλαροθήκες και το σκληρό αποτέλεσμα
Τεστ με στειλεό αποκαλύπτουν ότι υφάσματα όπως το βαμβάκι και το μετάξι βρίθουν από μύκητες και μικρόβια, εξαιτίας των νεκρών κυττάρων του δέρματος, του ιδρώτα και του σάλιου.
Τα πειράματα συνέλεξαν δείγματα από άπλυτες μαξιλαροθήκες και τα άφησαν να επωαστούν μέχρι επτά ημέρες, αποκαλύπτοντας βακτήρια που μπορούν να προκαλέσουν δερματικές λοιμώξεις και φλεγμονές.
Ο δρ. Χάντλει Κινγκ, δερματολόγος και κλινικός διδάσκων δερματολογίας στο Weill Medical College του Πανεπιστημίου Cornell, δήλωσε στο WellandGood:
«Όταν ξαπλώνετε στο κρεβάτι, μολύνετε τα κλινοσκεπάσματά σας με νεκρά κύτταρα του δέρματος (περίπου 50.000.000 την ημέρα), ιδρώτα, μακιγιάζ, μαλλιά και οτιδήποτε άλλο έχετε λάβει κατά τη διάρκεια της ημέρας, από γύρη και τρίχωμα κατοικίδιων ζώων μέχρι μυκητοειδή μούχλα και σωματίδια βρομιάς, αλλά και βακτήρια και σωματίδια ιών».
«Τα νεκρά κύτταρα του δέρματος και ο ιδρώτας αποτελούν τροφή για τα ακάρεα, προσελκύοντάς τα στο κρεβάτι σας και βοηθώντας τα να πολλαπλασιαστούν», πρόσθεσε.
Ο Κινγκ εξήγησε ότι ο ύπνος στην ίδια μαξιλαροθήκη για μία εβδομάδα μπορεί να προκαλέσει αλλεργίες, δερματικές μολύνσεις ή φλεγμονές του δέρματος.










